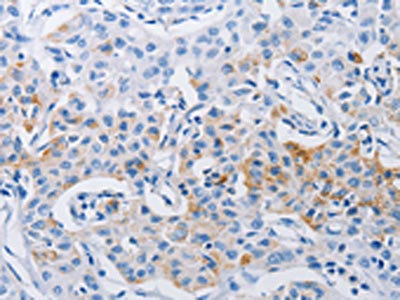

LRIG1 Antibody
-
中文名稱:LRIG1兔多克隆抗體
-
貨號:CSB-PA245012
-
規格:¥1100
-
圖片:
-
其他:
產品詳情
-
Uniprot No.:
-
基因名:
-
別名:Leucine rich repeat protein antibody; Leucine rich repeat protein LRIG1 antibody; leucine rich repeats and immunoglobulin like domains 1 antibody; Leucine-rich repeats and immunoglobulin-like domains protein 1 antibody; leucine-rich repeats- and immunoglobulin-like domains-cotnaining protein 1 antibody; LIG 1 antibody; LIG-1 antibody; LIG1 antibody; Lrig1 antibody; LRIG1_HUMAN antibody; Ortholog of mouse integral membrane glycoprotein LIG 1 antibody
-
宿主:Rabbit
-
反應種屬:Human
-
免疫原:Synthetic peptide of Human LRIG1
-
免疫原種屬:Homo sapiens (Human)
-
標記方式:Non-conjugated
-
抗體亞型:IgG
-
純化方式:Antigen affinity purification
-
濃度:It differs from different batches. Please contact us to confirm it.
-
保存緩沖液:-20°C, pH7.4 PBS, 0.05% NaN3, 40% Glycerol
-
產品提供形式:Liquid
-
應用范圍:ELISA,IHC
-
推薦稀釋比:
Application Recommended Dilution ELISA 1:1000-1:5000 IHC 1:50-1:200 -
Protocols:
-
儲存條件:Upon receipt, store at -20°C or -80°C. Avoid repeated freeze.
-
貨期:Basically, we can dispatch the products out in 1-3 working days after receiving your orders. Delivery time maybe differs from different purchasing way or location, please kindly consult your local distributors for specific delivery time.
-
用途:For Research Use Only. Not for use in diagnostic or therapeutic procedures.
相關產品
靶點詳情
-
功能:Acts as a feedback negative regulator of signaling by receptor tyrosine kinases, through a mechanism that involves enhancement of receptor ubiquitination and accelerated intracellular degradation.
-
基因功能參考文獻:
- MiR-183 overexpression promoted radioresistance of glioblastoma via down-regulating LRIG1 and increasing the activity of EFGR/Akt. PMID: 29793318
- LRIG1 is a negative regulator of RET2A and RET2B and is also downregulated in papillary and medullary thyroid carcinoma PMID: 29436694
- LRIG1 expression in human GC tissues is inversely correlated with miR-20a and EGFR. PMID: 29450946
- Role of LRIG1 in cancer [review] PMID: 27628597
- LRIG1 expression may represent a barrier to EMT PMID: 26387542
- LRIG1 role in the atrophic epidermis PMID: 28099467
- Downregulation of LRIG1 expression in oral verrucous carcinoma tissue is reported. PMID: 27509922
- LRIG1, as a negative mediated gene of tumor, can inhibit biological function of PAs via inhibiting PI3K/AKT and Ras/Raf/ERK pathways, and it might be a new target for gene therapy ofPituitary adenomas PMID: 27465333
- LRIG1 and Fascin-1 were differently expressed in cancer and normal lung tissue in patients with NSCLC, which could be a biomarker for mediastinal lymph node metastasis in NSCLC patients. PMID: 28230028
- Results suggest that the LRIG1could negatively control MRP-1 and the apoptosis to improve the sensitivity of VP16-related chemotherapy. PMID: 27183435
- ERa-dependent expression of LRIG1 dampens ErbB3 signaling in luminal breast cancer cells, and by blocking ERa activity with fulvestrant, LRIG1 is decreased thus permitting ErbB3 accumulation, enhanced ErbB3 signaling to cell survival pathways PMID: 26148232
- These findings demonstrate that LRIG1 is an independent prognostic factor in patients with non-small cell lung cancer PMID: 25813475
- LRIG1 expression was associated with pathological type, differentiation status, and stage of Non-small Cell Lung Cancer. The result showed that LRIG1 was an independent prognostic factor for OS of NSCLC patients. PMID: 26632716
- The inhibitory effects of LRIG1 are most likely mediated by suppression of the EGFR/PI3K/AKT pathway and epithelial-mesenchymal transition (EMT) process. PMID: 25860915
- LRIG1 can enhance chemosensitivity in glioblastoma by inhibition of BCL-2 and MnSOD PMID: 25449296
- Results showed that leucine-rich repeats and immunoglobulin-like domains can reverse multidrug resistance in glioblastoma, by negatively regulating epidermal growth factor receptor. PMID: 25801120
- MiR-20a mediated temozolomide-resistance in glioblastoma cells through negatively regulating LRIG1 expression. PMID: 25960225
- Based on these results, we concluded that the upregulation of LRIG1 expression inhibited the EGFR signaling pathway, activated the mitochondrial pathway of apoptosis and eventually increased the sensitivity of bladder cancer cells to CDDP. PMID: 25695283
- a subset of human duodenal tumors exhibited features of LRIG1(-/-) adenomas, including loss of LRIG1, gastric metaplasia (MUCIN5AC and MUCIN6), and increased amphiregulin and Egfr activity. PMID: 25794708
- LRIG1 is frequently methylated in human CRC and consequent mRNA and protein downregulation may contribute to tumor growth by activating EGFR/AKT signaling PMID: 26159916
- findings indicate that downregulation of LRIG1 is possibly a novel potential marker of transformation and tumorigenesis in OSSN cases. PMID: 24709893
- LRIG1 evolved in bladder cancer as a rare feedback negative attenuator of EGFR. PMID: 24314030
- These findings suggested that LRIG1-targeting siRNA can exert a dramatically inhibitory effect on RNA transcription and protein expression of LRIG1. PMID: 22528225
- Loss of LRIG1 was independently associated with risk of any relapse. PMID: 24879564
- USP8 is involved in deubiquitination of LRIG1, influencing the efficiency of Met degradation. PMID: 24828152
- LRIG1 immunoreactivity could be a clinically important prognostic marker in HPV-associated oropharyngeal cancer. PMID: 24548859
- LRIG1 downregulation in cancer cells enhances EGFR-MAPK-SPHK1 signaling and ECM remodeling activity, leading to malignant phenotypes of head and neck cancers PMID: 23624915
- LRIG1 mediates degradation of Met by SAIT301 and this degradation does not require Met activation. PMID: 23208509
- Downregulation of LRIG1 expression promotes the aggressive properties of glioma cells via EGFR/Akt/c-Myc activation. PMID: 23124613
- Data indicate that Lrig3 opposes Lrig1 negative regulatory action and enhances ErbB receptors ERBB2, ERBB3 and ERBB4 stability. PMID: 23723069
- LRIG1 inhibits EGFR expression and the downstream signaling activation, interferes with Bcl-2/Topo-2 expressions and eventually sensitizes glioma cells to TMZ PMID: 23850692
- High LRIG1 expression is associated with cervical adenocarcinoma progression. PMID: 23165628
- These findings suggest that upregulation of LRIG1 expression enhances the CDDP sensitivity in the glioma cell line U251. PMID: 23581227
- LRIG1 Loss of heterozygosity (LOH) is frequent across cancers and its loss is an early event in the development of human squamous carcinomas. PMID: 23208928
- This study revealed that the previously described up-regulation of EGFR and down-regulation of ERBB4 occurred in all analyzed renal cell carcinoma types, whereas down-regulation of ERBB2 and LRIG1 was only present in clear cell renal cell carcinoma. PMID: 22554477
- Cytoplasmic expression of LRIG1 is associated with meningiomas. PMID: 22484910
- Observations suggest the tumor suppressor function of LRIG1 is lost in a subset of colorectal cancers. PMID: 22464327
- our findings show that both upregulation of RTK signaling and attenuated TNFalpha expression caused by LRIG1 downregulation confers resistance to Smac mimetics PMID: 22241084
- ErbB2 activation antagonizes ERalpha-driven Lrig1 expression, providing a mechanistic explanation for Lrig1 loss in ErbB2-positive breast cancer. This work provides strong evidence for a growth-inhibitory role for Lrig1 in breast cancer. PMID: 21821674
- LRIG1 and LRIG2 expressions were seen in precancerous cervical epithelium and found to increase with increasing grade. PMID: 21632100
- LRIG1-transduced cells treated with cisplatin had more severe DNA damage, cellular apoptosis, growth inhibition and reversal of invasion PMID: 21431282
- LRIG1 was a marker for good prognosis after prostatectomy, which might be due to its growth inhibiting properties PMID: 21128282
- the LRIG1 ectodomain can be proteolytically shed and can function as a non-cell-autonomous regulator of growth factor signaling PMID: 21087604
- ERBB2 and LRIG1 copy number is increased in breast cancer PMID: 19490591
- Down-regulation of LIG-1 is associated with cancer PMID: 12234026
- Results demonstrate that LRIG1 is an integral cell-surface membrane protein that is expressed by specific cells in various human tissues and that its 143-kDa form might be cleaved into 111-kDa and 32-kDa fragments. PMID: 12684867
- downregulation of LRIG1 is associated with renal cell carcinoma PMID: 14520461
- LRIG1 evolved in mammals as a feedback negative attenuator of signaling by receptor tyrosine kinases PMID: 15282549
- LRIG1-mediated receptor ubiquitination and degradation may contribute to the suppression of ErbB receptor function PMID: 15345710
- A breast cancer linked gene is located within an amplicon containing the LRIG1 locus at 3p14.3. PMID: 16168117
顯示更多
收起更多
-
亞細胞定位:Cell membrane; Single-pass type I membrane protein.
-
組織特異性:Widely expressed.
-
數據庫鏈接:
Most popular with customers
-
-
YWHAB Recombinant Monoclonal Antibody
Applications: ELISA, WB, IHC, IF, FC
Species Reactivity: Human, Mouse, Rat
-
Phospho-YAP1 (S127) Recombinant Monoclonal Antibody
Applications: ELISA, WB, IHC
Species Reactivity: Human
-
-
-
-
-